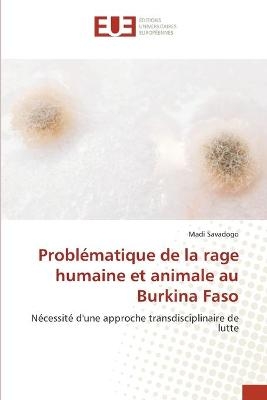
Problématique de la rage humaine et animale au Burkina Faso

Buch | Softcover
2020
|
International Book Market Service..
ISBN: 9786203156461
CHF 68,15 (inkl. MwSt)
- Keine Verlagsinformationen verfü
gbar